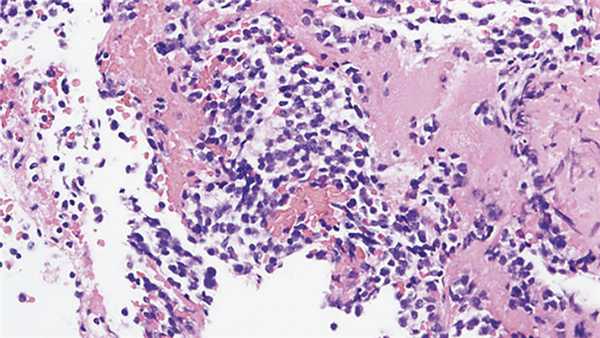

Компетенция стволовых клеток. Возможности дифференцировки стволовых клеток
Добавил пользователь Валентин П. Обновлено: 15.12.2025
Рак желудка (РЖ) является глобальной проблемой в здравоохранении. Несмотря на успехи в лечении, вследствие частого рецидивирования и метастазирования опухолей общий прогноз неблагоприятный [1]. Необходим поиск новых терапевтических подходов для улучшения клинических исходов РЖ. Модель раковых стволовых клеток (РСК) предложена для объяснения опухолевой гетерогенности, определяющей высокую частоту рецидивов и резистентность к системной терапии [2]. РСК идентифицированы во многих солидных злокачественных опухолях, включая РЖ. Воздействие на активное меньшинство РСК может увеличить эффективность терапии [3].
Опухолевая гетерогенность
Большинство опухолей имеет моноклональное происхождение, но к моменту обнаружения она состоит из генетически, эпигенетически и фенотипически гетерогенных клонов. Две основные концепции пытаются объяснить эту гетерогенность: гипотеза раковых стволовых клеток и модель клональной (стохастической) эволюции (рис. 1).
Модель клональной эволюции предполагает, что каждая опухолевая клетка обладает способностью инициировать образование опухоли. Прогрессия направляется редкими стохастическими событиями, происходящими во всех клетках. Клетки с мутациями, которые дают преимущество в росте, будут преобладать над остальными клетками опухоли и могут образовать новый клон, содержащий клетки различного фенотипа, имеющие различный пролиферативный потенциал 5.
Теория РСК, сформулированная в 1997 году [7], базируется на утверждении, что в структуре популяций опухолевых клеток существует четкая иерархия, на вершине которой находится популяция трансформированных клеток, имеющих сходные с нормальными стволовыми клетками свойства. РСК называют опухоль-инициирующими клетками (tumor-initiating cells, TIC) или опухоль-генерирующими клетками (tumor-propagating cells, TPC) [8,9]. Согласно концепции, популяция РСК:
- Составляет незначительную долю общей популяции клеток опухоли;
- Экспрессирует специфический набор поверхностных маркеров;
- Селективно поддерживает способность к онкогенезу в отличие от других популяций опухолевых клеток;
- Поддерживает рост гетерогенной массы, содержащей полный набор частично (или полностью) дифференцированных раковых клеток;
- Образует отдельный пул клеток, идентифицируемый биологическими и физико-химическими методами (по меньшей мере два пула клеток в опухоли: РСК и их производные — дифференцированные в разной степени клетки);
- Проявляет способность, подобно нормальным стволовым клеткам, к неограниченному самообновлению и дифференцировке по многим направлениям [9];
- Проявляет высокую устойчивость к стандартной терапии [2].
Рис. 1 | Модели опухолевой гетерогенности. А — эволюционная стохастическая модель; Б — иерархическая модель раковых стволовых клеток [5].
Самообновление желудочного эпителия и стволовые клетки желудка (СКЖ)
Строение слизистой оболочки желудка человека гистологически неоднородно. Принципиально отличают фундальные и антральные желудочные единицы [10]. Непрерывное клеточное обновление желудочного эпителия происходит за счет пролиферации и дифференцировки мультипотентных СКЖ, впервые обнаруженных в области перешейка желез. Эти недифференцированные клетки обладают двумя определяющими характеристиками. Во-первых, они способны длительно поддерживать свою популяцию (самообновление). Во-вторых, взрослые стволовые клетки являются источником всех клеточных линий желудочных единиц из-за асимметричных делений, ведущих к различным типам клеток-предшественников, которые пролиферируют (транзиторные амплифицирующиеся клетки) и дифференцируются в зрелые клетки (мультипотентность) [11]. В регуляции СКЖ участвуют следующие сигнальные пути: Wnt/[beta]-катенин (активация самоподдержания и ингибирование дифференцировки), киназа PI3K/Akt (рост, выживание и пролиферация клеток), трансформирующий фактор роста [beta] (TGF-[beta]) (ингибирующее влияние на пролиферацию клеток) и инсулиноподобный фактор роста 1. Ниша стволовых клеток образует сложную динамическую систему с нервной системой и сосудистым руслом [12].
Потомки стволовой клетки распространяются в двух направлениях (к просвету и к основанию железы) и образуют три основных клеточных линии с 11 типами клеток (рис. 2):
- Поверхностные (добавочные) мукоциты: прекурсоры поверхностных мукоцитов, поверхностные пре-мукоциты, зрелые поверхностные мукоциты (AAA лектин и TFF1);
- Главные клетки: прекурсоры шеечных мукоцитов, шеечные пре-мукоциты, зрелые шеечные мукоциты (GSII лектин и TFF2), предшественники зимогенных клеток и зрелые зимогенные клетки (внутренний фактор [GIF], пепсиноген, Mist1);
- Париетальные клетки: прекурсоры париетальных клеток, пре-париетальные клетки, париетальные клетки (H/K-АТФаза и VEGF).
Темпы обновления париетальных и зимогенных клеток ниже, чем остальных [13].

Рис. 2 | Схематическое изображение желудочной единицы человека и ее двунаправленного самообновления из мультипотентных стволовых клеток. Представлены стадии дифференцировки основных клеточных линий и некоторые из характерных секретируемых продуктов (предложена автором статьи на основе исследований [10,13,14,22]).
Также встречаются эндокринные клетки 5 основных типов: G-клетки (гастрин-продуцирующие), D-клетки (соматостатин-продуцирующие), энтерохромаффинные (EC) клетки (серотонин-продуцирующие), EC-подобные клетки (гистамин-продуцирующие) и X/A клетки (грелин-продуцирующие). В результате асимметричного деления мультипотентной СКЖ образуется эндокринный прогенитор (маркер Ascl1), под влиянием различных транскрипционных факторов подвергающийся коммитированию в определенную клеточную линию. Бипотентная клетка-предшественник D- и G-клеток экспрессирует маркеры NGN3 и PAX6. NKX6-3, PDX1 и ARX необходимые для ее дифференцировки в G-клетки, PAX4 требуется для продукции D-клеток. Интересно, что в теле желудка EC-клетки могут формироваться из неэпителиальных тучных клеток [14].
Молекулярные маркеры СКЖ обнаружены совсем недавно. Первым биомаркером стал виллин (Villin). Это специфичный для эпителиальных клеток кальций-регулируемый белок, модулирующий реорганизацию актиновых микрофиламентов. В отличие от активно пролиферирующих стволовых клеток перешейка, виллин-положительные СКЖ (V-СКЖ) находятся в состоянии покоя. Они расположены в нижней трети антральных желез [10].
Другая популяция СКЖ экспрессирует рецептор Lgr5, связывающий G-белок (Gpr49). Lgr5+ СКЖ (L-СКЖ) встречаются в основании фундальных и антральных желез в желудке эмбриона, но в постнатальном периоде ограничены антрумом. По аналогии с V-СКЖ, L-СКЖ также мультипотентны, но обладают высокой пролиферативной активностью [15]. Сосуществование активных и покоящихся стволовых клеток обнаружено в нескольких типах тканей. Считается, что активные стволовые клетки отвечают за физиологическое обновление ткани, а покоящиеся служат в качестве резерва, прежде всего, в случае травмы [16]. Особый интерес вызывает субпопуляция полностью коммитированных зимогенных клеток в основании фундальных желез, обладающих мультипотентностью. Эти клетки экспрессируют член суперсемейства рецепторов фактора некроза опухолей Troy. Troy+ клетки (Т-СКЖ) пролиферируют медленно и активируются после цитотоксического медикаментозного повреждения ткани [10].
Популяция СКЖ, экспрессирующая маркер Sox2 (S-СКЖ), рассеяна в перешейке фундальных и антральных желез, а также в их нижних частях. Они обладают мультипотентностью и имеют потенциал к самообновлению. Интересно, что S-СКЖ происходят из фетальных Sox2+ клеток-предшественников. S-СКЖ наиболее близки по характеристикам к СКЖ, первоначально обнаруженным в пролиферативной зоне перешейка [17].
Недавно была выделена новая популяция стволовых клеток (в позиции +4) в мышиной антральной железе с экспрессией рецептора к гастрину CCK2 (C-СКЖ). Они локализованы немного выше типичного расположения L-СКЖ. C-СКЖ способны подвергаться конверсии за счет гормонального триггера (обработка прогастрином, но не амидированным гастрином, приводит к переходу C-СКЖ в L-СКЖ) [18].
Важной проблемой является соотношение моноклонального происхождения желудочной единицы и факта неоднородности популяции стволовых клеток. Наиболее вероятной кажется конкурентная модель, которая предполагает достижение конкретной стволовой клеткой клонального доминирования [19]. СКЖ демонстрируют уникальную пластичность, перемещаясь в различных направлениях между стадиями мультипотентности и коммитированных прогениторов. Вероятным индуктором трансдифференцировки является Notch-сигналинг [20].
РСК в желудке
Поскольку РСК образуются из регионарных стволовых клеток [19], закономерно предположить связь СКЖ и РЖ. Для обнаружения предполагаемых маркеров РСК (табл. 1) были использованы два основных подхода. В первом использованы генетические манипуляции и трейсинг клеточных популяций РСК на мышиных моделях. Другой основан на изучении мышиных клеток из ксенотрансплантатов РЖ человека [21,22].
Таблица 1 | Обзор исследований иммуногистохимических маркеров РСК при РЖ.
Новая парадигма стволовых клеток

Классические представления о гемопоэтических стволовых клетках (ГСК) основываются на том, что поддержание количества клеток крови осуществляется уникальной клеточной популяцией со строго определенным набором характеристик: малочисленность популяции, экспрессия специфических маркеров, состояние «покоя», самообновление за счет асимметричного деления (одна из дочерних клеток полностью идентична материнской, вторая — вступает на путь дифференцировки до зрелой клетки и утрачивает стволовые свойства), однонаправленная дифференциация (невозможность вернуться в мультипотентное состояние и неизбежная гибель) [1, 2]. Эта иерархическая модель послужила стереотипным шаблоном в биологии стволовых клеток и долгое время считалась эталонной. Однако поиски популяции «профессиональных» стволовых клеток в большинстве других тканей не увенчались успехом. В связи с этим возник новый, более широкий подход к пониманию «стволовости» клетки: основополагающим моментом становится способность заменять погибшие клетки. Природа такой клетки может быть различной в условиях устойчивого состояния и в период регенерации тканей [3].
Регенеративный потенциал имеют весьма обильно представленные в конкретной ткани клоны клеток. Например, базальные клетки эпидермиса способны продуцировать клоны, которые со временем меняют форму и размеры, а также способны сохраняться в течение очень длительных периодов [4]. Обнаружение этого факта стало одним из первых поводов усомниться в том, что редкость (малочисленность), асимметричное деление или состояние покоя являются универсальными характеристиками стволовых клеток ткани взрослого организма.
Впоследствии в тканях других активно обновляющихся органов, структура которых включает большие популяции активно пролиферирующих клеток, также были обнаружены регенеративные способности. К таким органам относятся пищевод, кишечные крипты, железы слизистой оболочки желудка и яичко [5]. Как и в эпидермисе, пролиферативные клетки в каждом из этих компартментов имеют потенциал к генерации долгоживущей клеточной линии. Эти постоянно пролиферирующие клетки вынуждены конкурировать за ограниченное пространство стволовой ниши. Активное деление одной клетки может привести к вытеснению соседа, причем этот процесс носит стохастический (случайный) характер. Такая конкуренция в итоге формирует ткань, которая постоянно теряет клоны стволовых клеток, в то время как оставшиеся в нише клоны-«победители» становятся все многочисленнее [6].
Активно делящиеся потенциальные стволовые клетки в этих тканях не соответствуют классическим характеристикам ГСК. Они представлены в органе в изобилии и постоянно делятся по принципу симметричной модели (обе дочерние клетки идентичны материнской). Становится ли каждая из этих двух дочерних клеток фактически стволовой зависит от их местонахождения относительно нишевого пространства. Их продолжительность жизни не предопределена и может быть крайне вариабельна [7].
Поддержание относительного постоянства данной популяции стволовых клеток обеспечивается микроокружением, главным образом, размерами стволовой ниши.
Необратимость процесса клеточной дифференцировки также не абсолютна. Существует пул так называемых резервных стволовых клеток. Он формируется из частично или даже полностью дифференцированных клеток при повреждении тканей (рис. 1) [5, 8, 9]. Такая экстренная мобилизация клеток характерна для печени. Помимо гепатоцит-индуцированной регенерации, потенциально стволовой клеткой является и холангиоцит. Когда различные токсины, вирусы или наследственные дефекты метаболизма приводят к повреждению практически всех гепатоцитов, в ткани печени возле желчных протоков обнаруживаются клетки, экспрессирующие маркеры дедифференцировки (эпителиальную молекулу клеточной адгезии EpCAM или транскрипционный фактор Sox9). Эти овальные клетки (или атипичные протоковые клетки) обеспечивали регенерацию обоих типов клеток (как холангиоцитов, так и гепатоцитов) in vivo на мышиных моделях, у которых пролиферация гепатоцитов генетически заблокирована. «Профессиональных» стволовых клеток в печени не обнаружено, и ее уникальная способность к регенерации обеспечивается за счет пластичности двух эпителиальных клеточных линий — гепатоцитов и холангиоцитов [8, 9].
.

(A) Печень: производные энтодермы (холангиоциты и гепатоциты) имеют способность пролиферировать и восстанавливать оба типа клеток.
EpCAM+ — молекула клеточной адгезии эпителия
Альбумин+ — экспрессия специфичного для гепатоцитов белка
(B) Клональные органоиды, полученные из гепатоцитов [7] или холангиоцитов [8], могут длительно пролиферировать (на рисунке d - срок культивирования в днях) и трансдифференцироваться между собой.
(C) Дифференцированные главные клетки могут вносить вклад в обновление всех других типов клеток в железах желудка.
(D) В альвеолах альвеолоциты типа 2 (большие или гранулярные) могут действовать как резервные стволовые клетки и генерировать как тип 2, так и тип 1 (плоские или респираторные) [5].
Плюрипотентные стволовые клетки (эмбриональные стволовые клетки, а также
индуцированные плюрипотентные стволовые клетки) могут быть культивированы в течение длительных периодов времени, находясь в состоянии постоянной пролиферации. Отсутствие у данного типа клеток состояния покоя не исключает их способности служить источником всех типов тканей здоровой мыши при инъекции в бластоцисту [5].
Из приведенных примеров становится ясно, что клеточные парадигмы одной системы организма не должны быть экстраполированы на другие. Ткани значительно различаются по размерам клеток и гистоархитектонике, они имеют уникальные физиологические функции и подвергаются различным физическим, химическим и биологическим изменениям. Нет веских оснований предполагать, что эволюция «оснастила» каждый из наших органов универсальным механизмом поддержания целостности тканей. Более вероятно наличие индивидуальных «смарт»-стратегий функционирования стволовых клеток в каждом компартменте.
Зачем нужны стволовые клетки
Сердце бьется, мозг, почки, печень работают, волосы отрастают — мы настолько привыкли к этим процессам, что не задумываемся о том, как и почему они происходят в нашем организме. А ведь за каждым из них стоит неусыпная работа маленьких трудяг — клеток. И среди них есть особенные клетки — стволовые, из которых и произошли все клетки нашего организма. По сути мы, как любой многоклеточный организм, зародились из одной стволовой клетки.
Впервые термин «стволовая клетка» в начале ХХ века ввел в оборот российско-американский гистолог Александр Максимов на заседании гематологов в Берлине. Термин отлично передает суть того, как развиваются клетки любого организма (stem — это ствол/стебель, а cells — клетка). Подобно дереву, ствол — это родоначальная клетка, а ветки и листья — результат ее развития и изменения.
На ранних этапах эмбрионального развития стволовая клетка умеет производить разные типы клеток. Когда человек вырастает, стволовые клетки специализируются и могут производить только клетки определенных типов. Благодаря функции стволовых клеток наш организм постоянно обновляется.
— Например, постоянно гибнут миллионы лимфоцитов крови, они должны из чего-то восстанавливаться. — Из стволовых клеток крови. Мы сбрасываем очень много кожи, эпидермиса, целые граммы в день. А кожа должна восстанавливаться. Из чего? — Из стволовых клеток кожи, — поясняет доктор биологических наук, профессор, заведующий лабораторией эпигенетики Института общей генетики Российской академии наук Сергей Киселев.
Заменить больную иммунную систему на здоровую

Срок жизни различных тканей организма мал и если бы стволовые клетки не обновляли его, цивилизация попросту исчезла. Так, волосы на голове живут не больше семи лет, кровь обновляется каждые четыре месяца, а скелет — каждые 10 лет.
Используя способность стволовых клеток восстанавливать ткани, ученые сегодня способны лечить заболевания, которые еще пятьдесят лет назад считались приговором. Сегодня трансплантация костного мозга — одно из самых продвинутых направлений в медицине.
— Самые частые показания для проведения трансплантации — опухолевые заболевания системы крови. Даже после ремиссии на химиопрепаратах иммунная система человека с большой вероятностью снова не распознает опухолевую клетку и пойдет рецидив, что так или иначе со временем приведет к смерти. А трансплантация костного мозга — пожалуй, единственный метод, который позволяет достичь излечения, — уточняет научный сотрудник отделения трансплантации костного мозга национального медицинского исследовательского центра гематологии Михаил Дроков.
Донорство костного мозга — это опасно?
Химиотерапия убивает не только раковые, но и стволовые клетки, от чего страдает иммунная система организма. Трансплантация стволовых клеток — это вариант заменить больную иммунную систему на здоровую, которая будет в состоянии бороться с раковыми заболеваниями крови.
Как это происходит? Из кости таза донора берется пункция ста миллилитров костного мозга. Процедура рядовая и безопасная. Чаще всего донорами становятся родственники, но при условии иммунологической совмести, им может стать и посторонний человек. К 2012 году количество трансплантаций костного мозга в мире превысило один миллион операций.
А если несовместимость? Тогда велик риск осложнений, когда новая иммунная система начинает бороться не с болезнью, а с самим организмом пациента. Открытие системы HLA позволило адекватно подбирать доноров и создавать иммуносупрессанты,способствующие распознаванию иммунной системой донора не всего организма в целом, а только опухолевых клеток.
А что еще умеют стволовые клетки?

Генная терапия с использованием аденовирусного вектора. В некоторых случаях аденовирус вставляет новый ген в клетку. Если лечение успешно, то новый ген будет производить функциональный белок, что приводит к выздоровлению.
Сейчас медики думают, как можно научиться с помощью стволовых клеток костного мозга бороться с генетическими заболеваниями с самого рождения. Так, можно модифицировать стволовые клетки костного мозга пациента, взяв поврежденный ген и заменив его на здоровый. По замыслу ученых это поможет победить на генном уровне такие заболевания, как сахарный диабет, ВИЧ, бесплодие и дальтонизм.
Примечательно, что для того, чтобы проникнуть в клетку и встроить нужный ген, исследователи используют… вирус. Не цельный и не инфицирующий, а микроскопическую его часть, чтобы встроить нужный ген в геном. Это направление получило название генотерапия.
Органы в «пробирке»
Эмбриональные стволовые клетки способны формировать более 350-ти клеток костей, кожи, мозга и других органов. Но где их взять?
Настоящей сенсацией стали в 2006 году лабораторные исследования японского ученого Cинья Яманака, доказавшего, что можно взять любую клетку взрослого человека и путем генного перепрограммирования вернуть ее в состояние эмбриональной.
Российские ученые не отстают. Так, в московском медико-стоматологическом университете смогли вырастить из стволовых клеток …зубы. Для этого исследователи использовали стволовые клетки кожи и мезенхимальные — из жировой ткани и пульпы зубов. Первыми пациентами, у которых из подсаженных зачатков выросли искусственные зубы и на сколы старых зубов наросла эмаль, стали мыши. Приживаемость — почти 100%.
Следующий этап — адаптация технологии для человека и поиск решения, как вырастить зуб необходимого вида, например, передний резец или моляр.
— Это крайне важно, потому что из эмбриональной стволовой клетки мы потом можем получить любой специализированный тип ткани, из этой клетки получить и кровь, и кожу, и кости, и нейроны, и клетки-компоненты глаза, например, и все разнообразие тканей человека, — подтверждает д.б.н., профессор, заведующий лабораторией эпигенетики Института общей генетики РАН Сергей Киселев.
Параллельно российские ученые работают над проблемой алопеции. Они уже научились конструировать в пробирке волосяной фолликул для дальнейшей пересадки человеку обратно. Но в экспериментах, опять-таки на грызунах, столкнулись с неожиданной проблемой — пересаженные в холку лысым мышкам волосы выросли густым пучком, но в разных направлениях, куда им вздумается, и даже прорастали вовнутрь. И тут нашлись принципиально новые подходы — клонировать, мультиплицировать волосы для пересадки в поредевшие места или пересаживать даже не готовые луковицы, а их клетки, и давать фолликулам образовываться самим. К сожалению, применение этого метода возможно только, если хоть что-то от собственных волос осталось.
— Мы научились выделять специализированные клетки волосяного фолликула, которые также могут быть использованы для того, чтобы увеличить размер собственных волосяных фолликулов, то есть придать волосам толщину, а также, что самое главное, пробудить спящие волосяные фолликулы, которые смогут снова образовывать стержень, — поясняет заведующая лабораторией клеточной биологии института биологии и развития РАН, член-корреспондент РАН, д.б.н.Екатерина Воротеляк
Биопринтер — наше будущее?

А как выращивать более сложные, чем зубы и волосы, органы? Пока сосуды и органы, состоящие из различных типов тканей, вырастить в пробирке невозможно. Так появился метод биопечати.
— Это создание трехмерных ткане-инженерных или, как мы их еще называем, органных конструкторов с использованием клеточного материала, — это принципиально важно, из живых клеток по заданной трехмерной модели. Собственно, эта технология была разработана в начале 2000-х годов, много было взято из технологии классической 3D-печати, — рассказывает исполнительный директор компании-разработчика биопринтеров Юсеф Хесуани.
На 3D принтере стало возможным печатать не только чехлы для телефонов и бытовую технику, но и органы. К примеру, биопечатная щитовидная железа отлично прижилась в теле мыши и даже через несколько месяцев уровень гормонов зверька остался в норме. Это стало возможном благодаря специальным биочернилам, которые состоят из сфероидов — микроскопических шариков, в основе которых тысячи стволовых клеток нужной специализации.
Упрощенно суть биопечати выглядит так. Из кирпичиков-сфероидов, наполненных стволовыми клетками нужного типа, принтер выкладывает слои. Цементом служит гидрогель. Слои чередуются. В зависимости от того, какую функцию будет выполнять орган, специалисты по биопринтингу решают, нужно ли сохранить биологическую форму, или достаточно оставить лишь функцию. С примером щитовидной железы важна не форма, а внутренняя структура. А если дело касается сосудов или части трахеи, то здесь форма предопределена индивидуальными анатомическими особенностями, поэтому за основу 3D-модели берут, к примеру, файл компьютерной томограммы.
Конечно, квадратные почки и треугольное сердце вряд ли кому-нибудь нужны. Со временем точность и эффективность биопринтеров вырастет и специалисты научатся создавать точные копии поврежденных органов. Как внутренних, так и внешних. Человечество дождется момента, когда стволовыми клетками можно будет вылечить любой недуг.
Мифы и спекуляции
Во всем мире множество клиник предлагают лечение стволовыми клетками. И такие предложения надо очень внимательно проверять.
— Если у вас болит коленка, они вам введут клетки в коленку. Если у вас завтра заболит, голова, они введут в голову. Если заболит рука, введут и туда. Им все равно, куда вводить, им главное продать, стоимость процедуры от $5000 до $50 000. Все будет сделано по вашему желанию. И подобные клинике, к сожалению,найдутся в любой стране мира, — сетует Сергей Киселев.
В 2009 году история американца Джимма Гэсса всколыхнула научный мир. При обследовании в его теле обнаружили огромное новообразование, но не раковое, а гигантское бесформенное скопление клеток. другого человека! Оказалось, что ранее мужчина проходил терапию стволовыми клетками. Ученым все сразу стало понятно. Дело в том, что стволовые клетки, если их ввести в кровоток, не могут самостоятельно найти пораженное место и вылечить его. Для этого нужно подготовить условия. В противном случае они будут просто гулять по кровяной системе, и в результате, как в данном случае, скопятся в одном месте.
— Если мы возьмем стволовые клетки из костного мозга или из крови (это возможно сейчас) и введем просто человеку в вену, то получим …ровно ничего. Они исчезнут, уйдут в легкие, в печень и разрушатся. Они умрут, — генеральный директор ФГБУ «НМИЦ гематологии» Минздрава России, Валерий Савченко.
Именно поэтому сегодня исследования и эксперименты с использованием стволовых клеток во многих странах находятся под строжайшим контролем.
Тем не менее, клеточные технологии постепенно становятся одним из главных инструментов медиков. Стволовые клетки уже успешно применяются при лечении более сотни серьезных недугов — онкологических заболеваний крови, при лечении сосудов, кожных заболеваний, дистрофии сетчатки глаза.
Мы живем в эпоху открытий. И, возможно, человечество в скором времени забудет об институте донорства. А все нужные для трансплантации органы будет выращивать в пробирке из собственных клеток пациента или печатать.
Трансплантация костного мозга и стволовых клеток
Трансплантация костного мозга (ТКМ) / стволовых кроветворных клеток периферической крови (ТСКК) - метод лечения гематологических, онкологических и аутоиммунных заболеваний, при котором пациенту после проведения интенсивной иммуносупрессивной терапии с применением больших дозы цитостатических препаратов (иммуносупрессантов), вводят предварительно заготовленный костный мозг или стволовые кроветворные клетки периферической крови (СКК). Ежегодно в мире выполняется около 150 000 ТКМ и ТСКК, причем количество операций постоянно увеличивается.
ОБЩАЯ ИНФОРМАЦИЯ О СТВОЛОВЫХ КРОВЕТВОРНЫХ КЛЕТКАХ
Недифференцированная стволовая клетка, происходящая из бластоцисты, является родоначальницей всех клеток организма, в том числе и стволовой кроветворной клетки (СКК).

Основными свойствами стволовой кроветворной клетки являются возможность дифференцироваться в направлении любого из ростков кроветворения и способность к самоподдержанию.

Схема кроветворения и дифференцировки стволовых клеток
![]() Колонии стволовых кроветворных клеток (электронная микроскопия) | ![]() Мононуклеарная фракция, обогащенная клетками CD34, окрашена по Маю-Грюнвальду с докраской по Гимзе. Стволовые клетки, несущие маркер CD34, внешне напоминают малые и средние лимфоциты. |
ИСТОРИЧЕСКАЯ СПРАВКА
Первые работы, посвященные терапевтическому использованию костного мозга, были выполнены в последней декаде XIX века, независимо друг от друга Brown-Sequard, d"Arsonval, Fraser, Billings и Hamilton, которые применяли экстракт костного мозга животных для лечения больных различными видами анемий. Несмотря на положительный эффект, отмеченный всеми авторами, в течение последующих пятидесяти лет использование данной методики носило спорадический характер и не выходило за рамки клинического эксперимента до 1937 года когда Schretzenmayr впервые произвел парентеральное (внутримышечное) введение костного мозга, а в 1939 году Osgood выполнил первое внутривенное введение костного мозга.
Результаты экспериментальных исследований привели клиницистов к идее использования ТКМ при заболеваниях, связанных с поражением костного мозга (лейкозы, апластическая анемия), а также при радиационных воздействиях и проведении химиотерапии, однако основные теоретические и практические проблемы проведения ТКМ удалось преодолеть в 60-е годы. С этого времени ТКМ является одним из методов лечения различных заболеваний крови и иммунной системы.
ВИДЫ ТРАНСПЛАНТАЦИИ КОСТНОГО МОЗГА
- 1)аллогенную (АллоТКМ) - при которой больному вводится костный мозг от родственного или неродственного совместимого донора;

Разновидностью АллоТКМ является сингенная ТКМ (трансплантация от однояйцевого близнеца).
- 2)аутологичную (АутоТКМ) - когда реципиент получает предварительно заготовленный собственный костный мозг;

ПОКАЗАНИЯ К ТРАНСПЛАНТАЦИИ КОСТНОГО МОЗГА
- 1) острые лейкозы;
- 2) хронический миелолейкоз;
- 3) тяжелая апластическая анемия;
- 4) гемоглобинопатии;
- 5) врожденные иммунодефициты и нарушения метаболизма.
- 1) злокачественные лимфомы;
- 2) некоторые солидные опухоли;
- 3) аутоиммунные заболевания.
С развитием появлением колониестимулирующих факторов и развитием технологий клеточной сепарации с 70-х годов для получения гемопоэтических клеток крови вмести костного мозга стали использовать стволовые клетки периферической крови.
Применение клеточных сепараторов значительно упростило проведение процедуры получения стволовых клеток крови, уменьшило число осложнений связанных с дачей наркоза и травматическим повреждения костной ткани.

Сепаратор клеток крови
Еще одним потенциальным источником СКК является пуповинная кровь, основным преимуществом которой является меньшая иммуногенность, однако малое количество стволовых клеток в материале ограничивает ее применение и используется преимущественно в педиатрии или у пациентов с массой тела до 50 кг.
Методика проведения миелотрансплантации различается в зависимости от ее вида (аллогенная или аутологичная), нозологической формы заболевания и ряда других факторов.
ПРАКТИЧЕСКИЕ АСПЕКТЫ МИЕЛОТРАНСПЛАНТАЦИИ
- 1) определение показаний и противопоказаний;
- 2) выбор донора (при аллогенной трансплантации);
- 3) получение костного мозга/стволовых клеток их обработка, хранение и введение;
- 4) кондиционирование (иммуносупрессивная терапия);
- 5) профилактика и лечение осложнений периода цитопении;
- 6) профилактика и лечение поздних осложнений.
ОПРЕДЕЛЕНИЕ ПОКАЗАНИЙ И ПРОТИВОПОКАЗАНИЙ
Наиболее частыми показаниями к ТКМ/ТСКК являются онкогематологические и гематологические заболевания (лейкозы, злокачественные лимфомы, апластическая анемия, врожденные иммунодефициты и нарушения метаболизма).
Чаше всего ТКМ или ТСКК проводится во время полной ремиссии (ПР), частичной ремиссии (ЧР) или при рецидиве опухоли, чувствительном к химиотерапии. При первичной резистентности к цитостатической терапии результаты ТКМ резко ухудшаются, поэтому в этих случаях операция выполняется относительно редко.
При некоторых заболеваниях трансплантация является методом выбора (тяжелые формы апластической анемии, гемоглобинопатии, врожденных иммунодефицитов и нарушений метаболизма). В ряде случаев ТКМ/ТСКК проводится при солидных опухолях и аутоиммунных заболеваниях. Данная методика имеет возрастные ограничения: АутоТКМ/ТСКК может быть выполнена у лиц моложе 65 лет, АллоТКМ от HLA-идентичного родственника - моложе 55 лет, неродственная АллоТКМ - моложе 50 лет.
- 1) нарушении функции внутренних органов (почек, печени, легких, сердечно-сосудистой системы);
- 2) активной инфекции;
- 3) плохом общесоматическом статусе (индекс ВОЗ > I)
- 4) резистентном к химиотерапии рецидиве солидной опухоли или
- онкогематологического заболевания;
- 5) рефрактерности к трансфузиям тромбоцитов.
ВЫБОР ДОНОРА
Совместимость костного мозга определяет результаты АллоТКМ. Родственными донорами считаются совместимые по системе HLA братья или сестры реципиента (сибсы). Родители и дети гаплоидентичны (имеют одну общую хромосому из каждой пары, т. е. совпадают между собой на 50%) и не могут быть донорами аллогенного костного мозга. Совместимые сибсы имеются лишь у 20-25% больных, в связи с чем в последние 10 лет активно внедряется АллоТКМ от неродственных HLA-идентичных доноров или частично совместимых родственных доноров.
МОБИЛИЗАЦИЯ, ОБРАБОТКА И ИНФУЗИЯ СТВОЛОВЫХ КРОВЕТВОРНЫХ КЛЕТОК
Аспирация костного мозга производится под эндотрахеальным наркозом из задних гребней подвздошной кости, при необходимости - также из передних гребней и грудины. Для этого используют удлиненные иглы типа иглы Кассирского и шприцы объемом 20 см3, содержащие гепарин. Во избежание значительного разведения периферической кровью из каждого прокола кости аспирируют не более 5-6 мл костномозговой взвеси, которую фильтруют и помещают в специальные контейнеры. В каждом контейнере подсчитывают количество ядросодержащих клеток. Для восстановления кроветворения при АутоТКМ требуется получить не менее 1,5x106 ядросодержащих клеток на кг массы тела реципиента, при родственной АллоТКМ - не менее 2х106/кг (у больных апластической анемией - не менее 3х106/кг), при неродственной АлТКМ - не менее 3х106/кг. Объем аспирируемой костномозговой взвеси составляет около 1,5 л.
Для сохранения жизнеспособного костного мозга перед АутоТКМ (между аспирацией и инфузией клеток проходит от 2-3 недель до нескольких лет) после фракционирования его консервируют в жидком азоте под защитой криопротектора (чаще всего - диметилсульфоксида).
![]() А) | ![]() Б) |
Б) извлеченный из сосуда контейнер с костным мозгом
Инфузия аллогенного, размороженного аутологичного костного мозга или СКК периферической крови проводится внутривенно, капельно после предварительного введения антигистаминных препаратов для предотвращения аллергических реакций.

Инфузия костного мозга пациенту
ИММУНОСУПРЕССИВНАЯ ТЕРАПИЯ (КОНДИЦИОНИРОВАНИЕ)
Задача кондиционирования - обеспечить глубокую депрессию иммунной системы, а при онкологических заболеваниях и уничтожение оставшихся опухолевых клеток при умеренной токсичности для других органов и систем, а также создании условий для успешного приживления трансплантата.
Для проведения кондиционирования используются стандартные протоколы, в которых указываются дни, часы, дозы и длительность введения цитостатиков, симптоматических препаратов (антибактериальных, седативных, противорвотных и др., объем и характер инфузии), при необходимости - порядок проведения лучевой терапии. Протоколы кондиционирования различаются в зависимости от характера заболевания и типа трансплантации.
ПРОФИЛАКТИКА И ЛЕЧЕНИЕ ОСЛОЖНЕНИЙ ПЕРИОДА ЦИТОПЕНИИ
Вскоре после окончания кондиционирования и введения СКК у больного развивается аплазия костного мозга (период отсутствия костного мозгового кроветворения), которая проявляется практически полным отсутствием клеток крови (панцитопенией) и продолжается в среднем 4 недели. Этот период опасен развитием тяжелых осложнений (инфекции, кровоточивость и т.д.).
Основную опасность в периоде цитопении представляют инфекционные осложнения, поэтому их профилактика, своевременное и адекватное лечение являются необходимым условием успешной ТКМ.
- 1) помещение больного в стерильный бокс и проведение необходимых санитарно-гигиенических мероприятий (обработка кожи, слизистых оболочек и перианальной области дезинфицирующими растворами);
- 2) подавление микрофлоры кишечника с помощью антибактериальных и противогрибковых препаратов.
Также по показаниям проводится переливание компонентов крови (эритроцитарная масса, тромбомасса, плазма).
Что такое стволовые клетки и как их получают?

С каждым годом о стволовых клетках говорят все чаще: они используются в различных областях медицины, а также в косметологии. Но что такое стволовые клетки, откуда их берут, и каждый ли человек имеет доступ к этому уникальному оздоровительному ресурсу?
Что такое «стволовые клетки»
Это так называемые «незрелые» или недифференцированные клетки, которые есть в организме каждого живого многоклеточного существа. То есть, организм любого млекопитающего, в том числе, человека, снабжен определенным «запасом» стволовых клеток. Их главные особенности — возможность самообновляться и образовывать новые такие же клетки, делиться, а также принимать функции любых тканей и органов (это называется дифференциацией клеток). Впервые термин «стволовая клетка» стали использовать в 1909 году. Роль этих клеток изучали ученые во многих странах мира в течение практически всего ХХ века, постоянно дополняя знания о роли стволовых клеток в организме и возможностях их использования. Также применяется термин «аутологичные» (собственные) стволовые клетки.
Из стволовых клеток в период внутриутробного развития формируются все внутренние органы, сосуды, кожа, все остальные ткани. Так как процесс дифференциации клеток происходит до рождения, наибольшее количество стволовых клеток содержит именно развивающийся организм, а к моменту появления на свет больше всего стволовых клеток сохраняется в пуповинной крови, ткани пуповины и плаценте.
В организме взрослого человека тоже есть стволовые клетки. Это своего рода «ремкомплект», которые организм использует для того, чтобы помочь восстановлению и обновлению органов и тканей. Но чем старше человек, тем стволовых клеток меньше, и тем меньше возможностей «починить» пострадавший орган. Снижение количества стволовых клеток и замедление их производства организмом — естественный процесс, являющийся частью процесса физического старения.
Лечение стволовыми клетками
В 70-х годах ХХ века стало популярным омоложение стволовыми клетками — «инъекции молодости», которые могли позволить себе западные актеры и советская партийная номенклатура: тем, кто не хотел поддаваться влиянию возраста и имел достаточно средств, вводили (трансплантировали) стволовые клетки для активизации процессов омоложения организма. Сегодня препараты стволовых клеток активно применяются в косметологии и геронтологии.
Огромный интерес и перспективы для науки представляют возможности биопрепаратов стволовых клеток в лечении многих болезней, в том числе — тяжелых и ранее считавшихся неизлечимыми. Список этих заболеваний достигает нескольких десятков.
Широкие возможности открывает терапия стволовыми клетками в реконструктивной медицине. Во многих странах мира, в том числе — в Украине их применяют при лечении химических и термических ожогов высокой степени. Благодаря способности стволовых клеток дифференцироваться в клетки любых тканей организма, они помогают восстановить поврежденный кожный покров на больших участках. Если при этом используются аутологичные стволовые клетки, отсутствует риск отторжения, возможный при применении донорского материала.
Еще одна перспективная сфера применения препаратов стволовых клеток — кардиология. Уже сейчас в Украине проводятся их клинические испытания при ишемической кардиомиопатии, нарушениях сократительной функции сердца. Биопрепарат стволовых клеток может помочь пациентам с тяжелыми сердечными патологиями выжить в ожидании трансплантации сердца.
В нашей стране также проводятся исследования эффективности препарата стволовых клеток при циррозе печени, у врачей в Украине и других странах уже есть практика успешного применения биопрепарата при тяжелых патологиях поджелудочной железы.
Использование недифференцированных клеток может продлить жизнь и значительно улучшить ее качество людям с сахарным диабетом. Известно, что при этом заболевании развиваются различные по степени тяжести поражения сосудов, из-за чего возникают трофические язвы на ногах, так называемая «диабетическая стопа», поражаются артерии. Сейчас на завершающей стадии клинические испытания препарата стволовых клеток при этих патологиях. Все эти исследования проводятся в Украине. В мире также получено много положительных результатов использования препаратов стволовых клеток при лечении рассеянного склероза, болезни Крона, болезни Паркинсона, сердечной недостаточности, ревматоидного артрита, лейкозов, злокачественных опухолей разных локализаций.
Стволовые клетки человека: какими они бывают
Стволовые клетки бывают разными в зависимости от происхождения, то есть — в зависимости от того, из какого исходного материала их получают. Кроме эмбриональных и фетальных стволовых клеток, получение которых имеет серьезные этические ограничения, существует также возможность выделения «незрелых» клеток без какого-либо вреда для организма, не противоречащая моральным и этическим нормам. К полученным таким образом стволовым клеткам относятся:
- Постнатальные («взрослые») стволовые клетки. Это клетки взрослого организма, которые, как уже было сказано, содержатся и производятся в нем в небольшом количестве. Проблема в том, что такие клетки часто находятся на определенной стадии дифференцировки, а это значительно сужает возможности их применения. Однако есть и преимущества: можно получить аутологичные постнатальные стволовые клетки, а это означает, что реципиент не будет их отторгать после трансплантации, так как это его собственный биологический материал.
- Стволовые клетки пуповинной крови. Относятся к постнатальным стволовым клеткам, но из всех клеток взрослого, зрелого организма они в наименьшей степени дифференцированы. Это означает, что в случае необходимости их можно использовать при широком спектре заболеваний, в геронтологии, восстановительной медицине, ведь они имеют наибольший «ремонтный» потенциал, дифференцируясь в клетки тех органов или тканей, которые необходимо «починить».
В зависимости от «задач», которые могут выполнять незрелые клетки организма, их разделяют на три вида:
- Гемопоэтические стволовые клетки называются также кроветворными, так как они дифференцируются в клетки крови. Они содержатся как в пуповинной крови, так и в костном мозге — именно их часто используют для трансплантации при злокачественных заболеваниях крови.
- Мезенхимальные стволовые клетки называют стромальными и мультипотентными. Их особенность заключается в способности дифференцироваться в клетки костной, хрящевой и жировой ткани. Эти клетки выделяют из пуповинной крови, пупочного канатика, плаценты. Они активно используются в терапии диабетической стопы (тяжелого осложнения сахарного диабета, при восстановлении кожных покровов), а также заболеваний опорно-двигательного аппарата, в частности — суставов.
- Тканеспецифичные клетки являются прогениторными, то есть, «клетками-предшественницами». Они содержатся в органах и тканях, организм задействует их при необходимости обновления клеточной массы того или иного органа или ткани. В отличие от других недифференцированных стволовых клеток, которые могут делиться неограниченное количество раз, тканеспецифичные клетки такой способности не имеют.
В терапевтических целях используют гемопоэтические и мезенхимальные стволовые клетки, чаще всего — выделенные из пуповинной крови, пупочного канатика и плаценты.
Стволовые клетки пуповинной крови: преимущества
Главная особенность стволовых клеток пуповинной крови — они могут быть аутологичными. Родители, сохранившие пуповинную кровь (а часто также пуповину и плаценту) родившегося ребенка, обеспечивают ему пожизненную страховку на случай тяжелого заболевания или травмы. Ежегодно в мире совершаются новые открытия в медицине, связанные с возможностями применения биопрепаратов стволовых клеток. Поэтому в будущем ребенок, имеющий такую «страховку», получит лекарство от множества возможных болезней. Так как выделенные стволовые клетки являются аутологичными, при трансплантации не возникнет иммунного конфликта и новые клетки не будут отторгаться организмом.
Одно из преимуществ сбора пуповинной крови — полная безопасность и безболезненность процесса. Получение стволовых клеток из этого биологического материала, а также из пупочного канатика и плаценты, не противоречит никаким этическим нормам.
Аутологичные стволовые клетки можно использовать не только непосредственно для ребенка, из крови которого они выделены. Они также в некоторых случаях могут подойти для лечения его родных братьев и сестер, иногда — кого-либо из родителей, ведь есть вероятность иммунного сходства с родными донора.
Из сохраненных стволовых клеток также можно получить биопрепарат, который используют в косметологических целях и в геронтологии для омоложения организма.
Итак, главные преимущества сбора и хранения клеток пуповинной крови и плаценты:
- Безопасность и доступность сбора в любом роддоме.
- Полное иммунное сходство при дальнейшем использовании.
- Возможность использования клеток для близких родственников.
- Этичность и гуманность: при выделении клеток организм не страдает и для него нет никаких рисков.
Хранение стволовых клеток
Стволовые клетки пуповинной крови, а также биологический материал, выделенный после сбора плаценты и пуповины, хранится в Криобанке. Здесь вы можете увидеть, как происходят все процессы, связанные с обработкой и хранением пуповинной крови, плаценты и пуповины, в нашем Криобанке.
После предварительной подготовки выделенные стволовые клетки подвергаются криозаморозке и сохраняются в специальных емкостях с жидким азотом любое количество времени. Как только они понадобятся владельцу, Криобанк выдаст их по первому требованию и доставит в полной сохранности в любую клинику, где будет использоваться биопрепарат. Все о хранении стволовых клеток пуповинной крови вы можете узнать на нашем сайте или у консультантов Криобанка Института клеточной терапии.
Читайте также:




